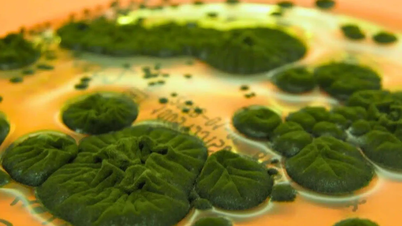
¿Podría el extraño hongo negro de Chernóbil ser resistente a la radiación?

Los animales que adoptan crías pueden ofrecer beneficios evolutivos, pero también puede deberse a otros factores como la empatía o la falta de experiencia.

Los gorilas de montaña ( Gorilla beringei beringei ) viven en grupos y adoptan crías huérfanas. Foto: SIMON MAINA/AFP
El acto de cuidar a un animal recién nacido huérfano y sin parentesco puede ocurrir porque proporciona una ventaja evolutiva a los padres adoptivos, según Michael Weiss, ecólogo del comportamiento y director de investigación del Centro de Investigación de Ballenas del estado de Washington. Por ejemplo, la adopción puede brindar una valiosa experiencia a las hembras que aún no han parido, aumentando las posibilidades de supervivencia de las futuras crías. La adopción puede ocurrir dentro de la misma especie o entre especies diferentes, aunque esto es extremadamente raro.
En un estudio de 2021 publicado en la revista eLife , un equipo de expertos examinó el impacto de la pérdida materna en los gorilas de montaña ( Gorilla beringei beringei ) y descubrió que los huérfanos mayores de dos años formaban vínculos fuertes con otros miembros de la tropa, particularmente con el macho dominante.
Los gorilas de montaña viven en manadas, generalmente compuestas por un macho dominante, varias hembras y crías. Independientemente de si el macho dominante es el padre de las crías, su función es proteger a la siguiente generación de la muerte a manos de machos rivales.
"Los machos que cuidan bien a sus crías y lo hacen delante de las hembras son muy apreciados. Cuidar de un polluelo huérfano puede dar ventaja al macho dominante, aumentando así las posibilidades de apareamiento y transmisión genética", explica Robin Morrison, autor del estudio publicado en la revista eLife y ecólogo conductual de la Universidad de Zúrich.
Morrison afirmó que las gorilas de montaña hembras de la tropa no se benefician necesariamente de criar crías huérfanas, pero tampoco gastan mucha energía, ya que las crías ya pueden buscar alimento por sí mismas al cumplir los dos años. Además, las demás crías tendrán más compañeros de juego, lo cual es positivo porque les ayuda a mejorar sus habilidades sociales.
La adopción también es común entre otras especies de primates y puede ayudar a conectar grupos. En un estudio de 2021 publicado en Scientific Reports , un equipo de expertos documentó el primer caso de un gran simio, concretamente una chimpancé pigmea ( Pan paniscus ), que adoptó a una cría de otro grupo. Sugieren que este comportamiento puede mejorar el estatus social de los adultos.
Otra posibilidad es que, al igual que los humanos, las hembras de chimpancé pigmeo sientan empatía y afecto por sus crías recién nacidas. Sin embargo, este afecto puede provocar secuestros y la muerte de las crías si se ven atrapadas en una situación caótica.
Los primates también pueden mostrar instintos de cuidado, como los humanos al ver una cría o un animal pequeño. Esto no es exclusivo de los primates, según Weiss, quien ha dedicado un tiempo considerable al estudio de las orcas ( Orcinus orca ) en las aguas que rodean el noroeste del Pacífico y el oeste de Canadá.

Un calderón joven nada con una orca. Foto: Orcas Islandesas
En 2021, científicos en Islandia descubrieron por primera vez una orca adoptando a una cría de calderón común ( Globicephala ). En junio de 2023, el equipo del Proyecto Orca Islandés también se sorprendió al ver a otra hembra con un comportamiento similar.
Weiss dijo que estos casos son un "gran misterio" porque los investigadores nunca han visto a los adultos de estas dos especies comunicarse entre sí, lo que significa que las orcas pueden haber secuestrado a las crías de ballenas piloto.
Una pregunta importante es qué beneficio aporta esto a las orcas. La producción de leche consume mucha energía, y las madres orcas amamantan a sus crías hasta por tres años. Dado que distrae y agota los recursos de la madre orca, las crías adoptadas también podrían causar problemas a sus propias crías.
El equipo de investigación sugiere que la orca hembra podría haberse sentido obligada a cuidar a un animal más pequeño porque ella misma había dado a luz recientemente. Varios otros factores podrían contribuir a este comportamiento de adopción, como la curiosidad, las habilidades sociales o la falta de experiencia. Esta última podría explicar el interés de la orca por el calderón. «Podría tratarse de un instinto maternal infundado», afirmó Weiss.
En especies no mamíferas, las madres inexpertas a veces cometen errores. Los cucos ( Cuculus canorus ) son parásitos adoptivos, lo que significa que las hembras ponen sus huevos en los nidos de otras especies para ahorrarse el cuidado. En un estudio de 1992 publicado en la revista Behavioral Ecology , los autores descubrieron que las hembras jóvenes del carricero común ( Acrocephalus arundinaceus ) eran engañadas con mayor facilidad por los huevos de cuco que las hembras mayores.
Thu Thao (según Live Science )
[anuncio_2]
Enlace de origen

Kommentar (0)